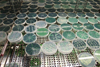

|
DNA블록을 픽셀처럼 이용 107가지 형상 시연 - 글자와 이모티콘
|
2012/06/01 |
|
DNA블록을 픽셀처럼 이용 107가지 형상 시연 - 글자와 이모티콘 || 유전자 침묵에 핵심적인 단백질의 구조 - 아고너트-2의 구조 || 생기 잃은 토종 제약…무기력 '심각' - 경영지표 엉망, 산업 종사자 사기도 최악 || 글로벌 암 발생 2030년까지 ...
|
|

|
인터넷 검색 엔진으로 암 찾아낸다 - 구글의 '페이지랭크' 알고리듬 활용
|
2012/05/31 |
|
인터넷 검색 엔진으로 암 찾아낸다 - 구글의 '페이지랭크' 알고리듬 활용 || CMT 등 한국인 대상 유전적 희귀질환 연구 절실 || 세계 최대 어린이 암환자 게놈지도 완성 - 어린이 암치료 획기적 발판 마련 || 항생제 개발의 위기와 새로운 모색 || 노안에...
|
|

|
고용량 분자 저장기술 개발 성공...KAIST EEWS 대학원 Yaghi 교수팀
|
2012/05/30 |
|
고용량 분자 저장기술 개발 성공...KAIST EEWS 대학원 Yaghi 교수팀 || 새로운 항암 약품인 Dinitroazetidines의 전임상 평가 || 생각보다 더 단순한 유전적 변이로 발암? || 유방암에서 Akt 단백질을 활성화시키는 새로운 E3 연결효...
|
|

|
'차세대 바이오연료 시대' 온다 - '에너지 미세조류 광합성 개량' 연구
|
2012/05/29 |
|
'차세대 바이오연료 시대' 온다 - '에너지 미세조류 광합성 개량' 연구 || 당분 과다 섭취 '머리 나빠진다' || 너무 깨끗해서 탈났다 … 전염병 백일해의 역설 || 세계 최대 수소타운 만든다 - 지경부, 200㎾ 연료전지 설비 90억 투입 || 미...
|
|
|
3D로 볼 수 있는 박테리아의 무기
|
2012/05/26 |
|
3D로 볼 수 있는 박테리아의 무기 || 콕사키 바이러스를 이용한 폐암치료 || 간디스토마에 의해 가려지는 우결핵 || 식물은 어떻게 계절변화를 인지하고 개화시기를 조절할까 || 줄기세포내 성장 인자, 다발성 경화증 회복을 돕는다 || 잡초와의 전쟁으로 우리의 땅...
|
|
|
